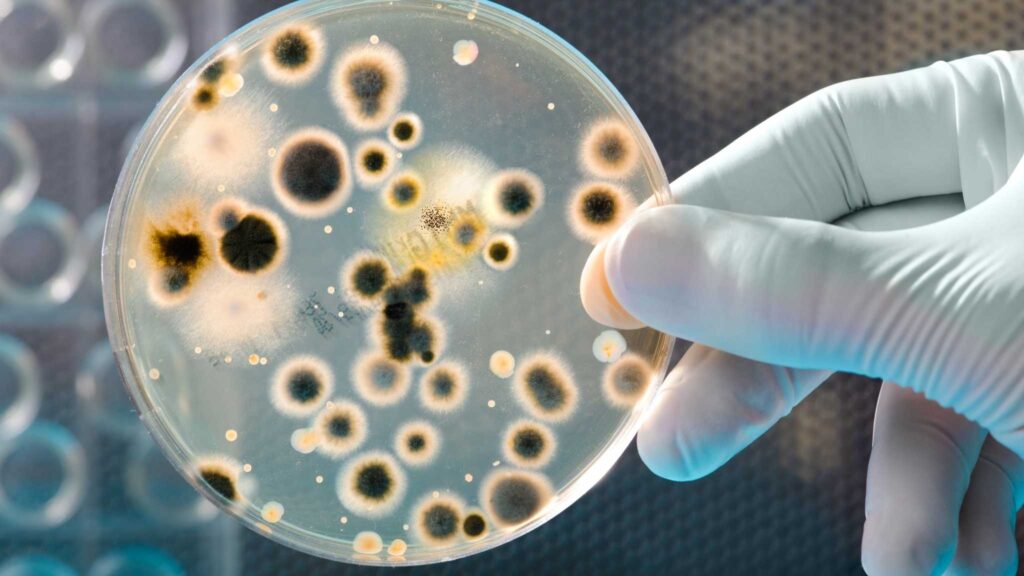

O consumo global de plásticos ultrapassa 400 milhões de toneladas por ano, e a maior parte é usada em embalagens descartáveis que geram impactos ambientais severos. Para enfrentar esse desafio, pesquisadores desenvolveram bioplásticos naturais a partir de açúcares obtidos de resíduos alimentares, oferecendo alternativas compostáveis aos plásticos convencionais.
Essa inovação utiliza polímeros de poli-hidroxialcanoatos (PHA) produzidos por microrganismos, que podem ser moldados em filmes ultrafinos e resistentes. O estudo, publicado na revista Microbial Cell Factories, demonstra que os bioplásticos podem reproduzir as propriedades físicas de plásticos comuns e ainda permitir ajustes finos em suas características.
Como os bioplásticos são produzidos
A produção envolve o uso de bactérias do solo, como Cupriavidus necator e Pseudomonas putida, que são alimentadas com uma mistura balanceada de açúcares, sais, nutrientes e oligoelementos. Durante o crescimento, os microrganismos armazenam plástico natural dentro de suas células. Posteriormente, o material é extraído e transformado em filmes ultrafinos com cerca de 20 mícrons de espessura.
Principais etapas do processo:
- Alimentação das bactérias com açúcares residuais;
- Armazenamento de polímeros dentro das células microbianas;
- Extração dos PHAs usando solventes;
- Moldagem em filmes finos e testes de propriedades mecânicas.
Esses filmes bioplásticos podem ser rígidos ou flexíveis, dependendo da cepa bacteriana usada, e a combinação de diferentes microrganismos permite ajustar a cristalinidade, o ponto de fusão e a resistência do material.
Aplicações e impacto ambiental
Os bioplásticos produzidos apresentam grande potencial para substituir embalagens de uso único, especialmente em filmes alimentícios e agrícolas, como embalagens de silagem. Além disso, suas propriedades ajustáveis abrem possibilidades para filmes médicos e outros produtos sensíveis à temperatura.
Benefícios dos bioplásticos de açúcares:
- Compostáveis junto com resíduos orgânicos;
- Propriedades físicas comparáveis aos plásticos convencionais;
- Versatilidade para diferentes aplicações industriais;
- Redução significativa do impacto ambiental de plásticos descartáveis.
Atualmente, equipes de pesquisa estão trabalhando em colaboração com empresas do setor para desenvolver soluções comerciais e ampliar o uso desses biopolímeros sustentáveis, contribuindo para um futuro mais verde e menos dependente de petróleo.